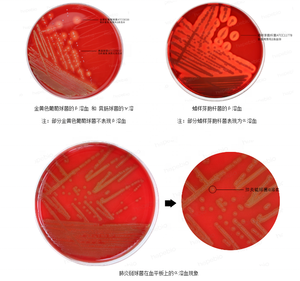

Изучение глюкозно кровяного агара Цейсслера: фотогалерея

Раздел: Другие животные